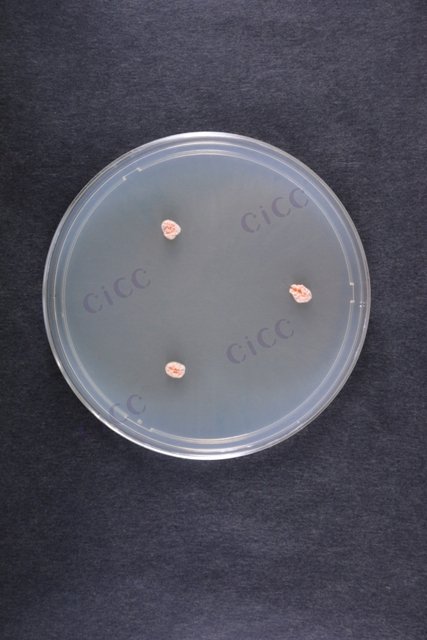
白色诺卡氏菌 Nocardia alba CICC 10555 Nocardia alba

白色诺卡氏菌 Nocardia alba CICC 10555 Nocardia alba
-
艾阿华诺卡氏菌 Nocardia iowensis CICC 10556 Nocardia iowensis
CICC 10556 | 见证书
-
微白诺卡氏菌 Nocardia exalbida
BNCC373209 | 冻干粉;斜面;菌液;平板
-
Nocardia alba
CICC 11035 | 见证书
-
黄玫瑰色诺卡氏菌 Nocardia flavorosea
BNCC152924 | 冻干粉;斜面;菌液;平板
-
亚洲诺卡氏菌 Nocardia asiatica
BNCC370011 | 冻干粉;斜面;菌液;平板
-
脓肿诺卡氏菌 Nocardia abscessus
BNCC382294 | 冻干粉;斜面;菌液;平板
-
南非诺卡氏菌 Nocardia transvalensis
BNCC361941 | 冻干粉;斜面;菌液;平板

说明书下载: 菌种说明书 打管说明书
您正在浏览的产品:白色诺卡氏菌 Nocardia alba CICC 10555
手机版:白色诺卡氏菌 Nocardia alba CICC 10555
本公司销售的所有产品仅供实验科研使用,不用于人体及临床诊断。